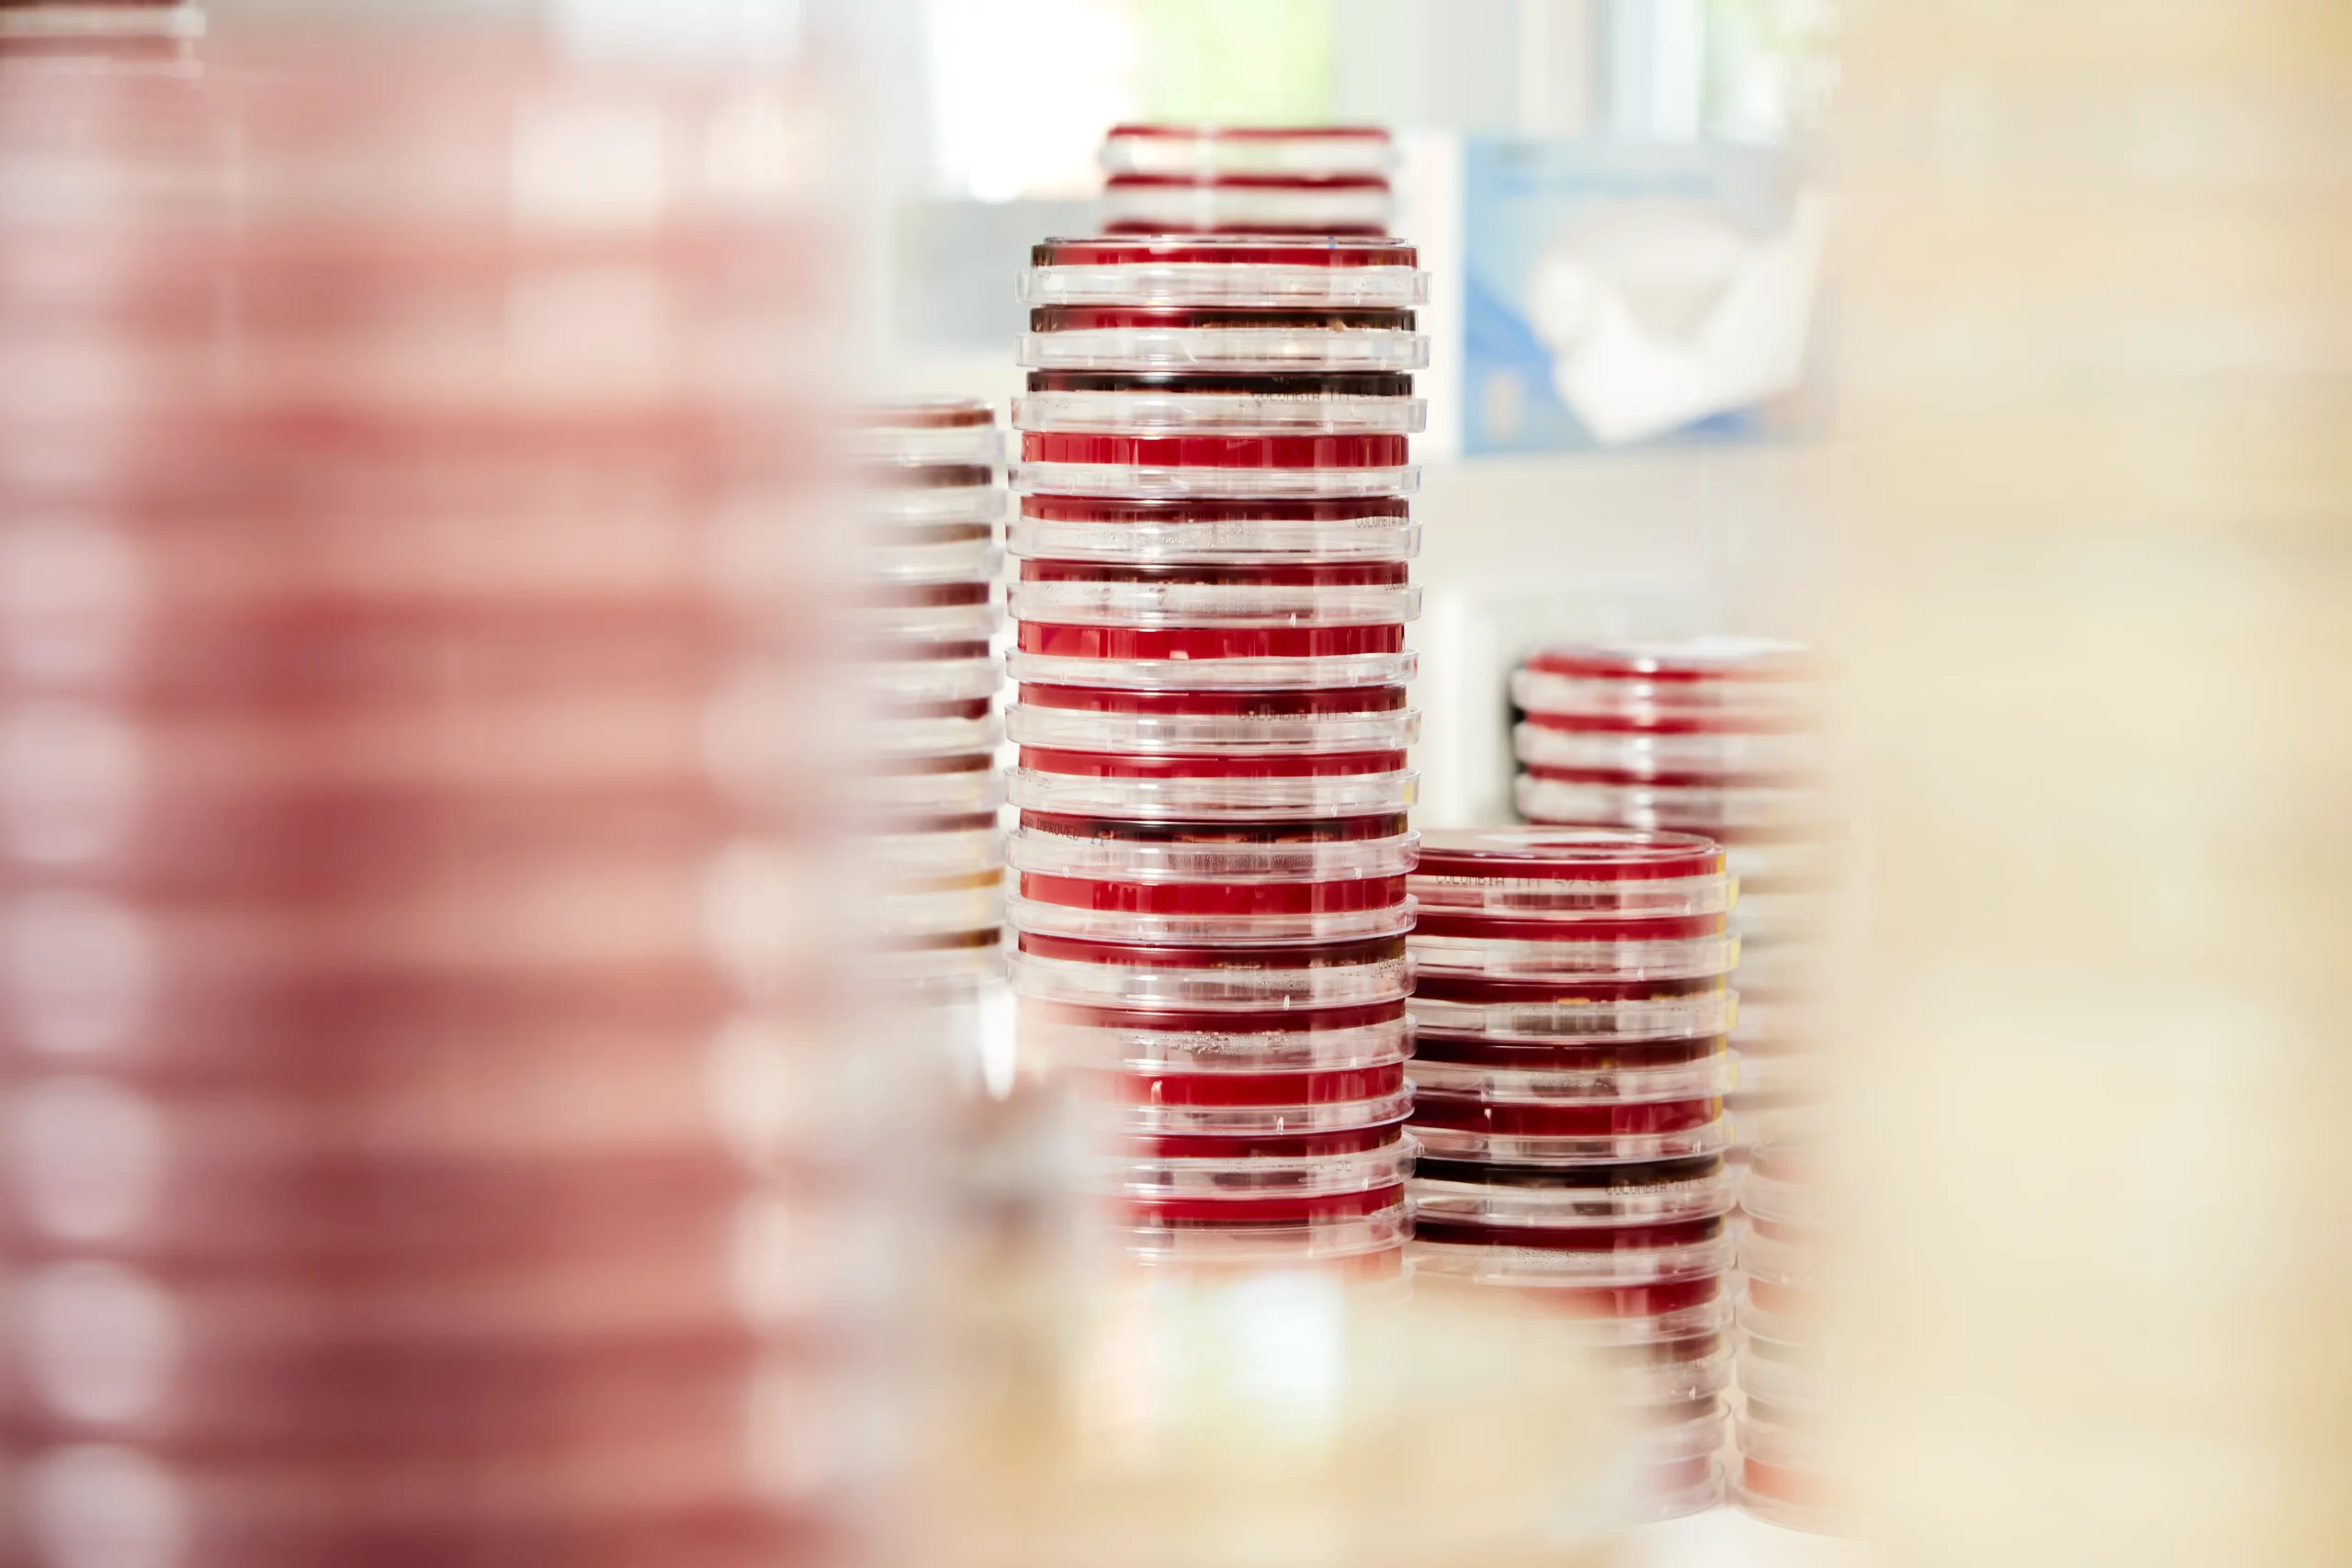

Impressum
IMPRESSUM
Labor Dr. Heidrich & Kollegen MVZ GmbH
Klinikweg 23
22081 Hamburg
Telefon: 040 – 97 07 999 – 0
Fax: 040 – 97 07 999 – 99
E-Mail: info@labor-heidrich.de
Internet: www.labor-heidrich.de
Geschäftsführer: Dr. Jens Heidrich
Amtsgericht Hamburg HRB 107 437
USt-IdNr. DE262239126
Zuständige Kassenärztliche Vereinigung: Kassenärztliche Vereinigung Hamburg
Gesetzliche Berufsbezeichnung: Arzt (verliehen in der Bundesrepublik Deutschland)
Zuständige Ärztekammer: Ärztekammer Hamburg
Berufsrechtliche Regelungen: Hamburgisches Kammergesetz für die Heilberufe, Berufsordnung der Hamburger Ärzte und Ärztinnen
Information gemäß § 36 Abs. 1 VSBG:
Das Labor Dr. Heidrich & Kollegen MVZ GmbH beteiligt sich nicht am Verbraucherschlichtungsverfahren nach dem Verbraucherstreitbeilegungsgesetz.


